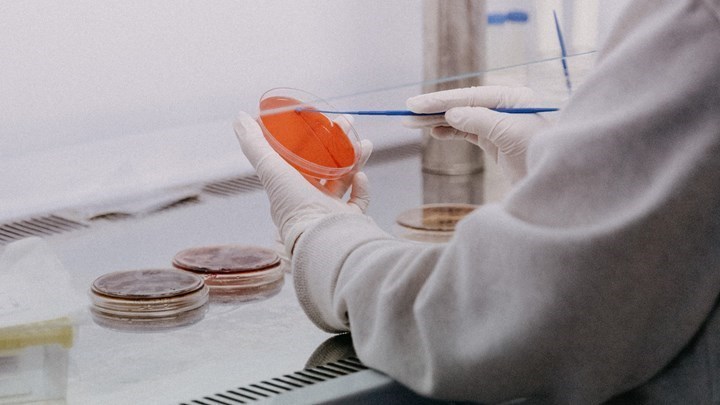
Κορονοϊός: Πόσο βοηθά η χορήγηση πλάσματος σε ασθενείς με αιματολογικές νεοπλασίες

H COVID-19 αποτελεί μία απειλητική για τη ζωή λοίμωξη για ορισμένες κατηγορίες ασθενών όπως αυτών με συννοσηρότητες καθώς και ασθενών με μειωμένη λειτουργία του ανοσοποιητικού συστήματος. Η παραγωγή αντισωμάτων αποτελεί μία βασική συνιστώσα της ανοσολογικής απάντησης η οποία είναι απαραίτητη για τον επιτυχή έλεγχο της λοίμωξης. Επιπλέον, η διέγερση της παραγωγής αντισωμάτων μέσω του εμβολιασμού κατά του SARS-CoV-2, είναι πολύ σημαντική για την πρόληψη της λοίμωξης.
Η χρήση του πλάσματος ιαθέντων, το οποίο λαμβάνεται από πλήρως αναρρώσαντες εθελοντές δότες πλάσματος και το οποίο περιέχει υψηλούς τίτλους αντισωμάτων έναντι του SARS-CoV-2, αποτελεί μία θεραπευτική επιλογή που έχει ήδη ευρέως δοκιμασθεί από την έναρξη της πανδημίας σε πολλά κέντρα. Τα αποτελέσματα διαφόρων μελετών διαφέρουν, πιθανότατα λόγω διαφορετικών πληθυσμών ασθενών και διαφορετικών μεθοδολογιών. Υπάρχουν πάντως αρκετές μελέτες παρατήρησης που δείχνουν ότι η θεραπεία αυτή είχε σαν αποτέλεσμα την βελτίωση της κλινικής κατάστασης των ασθενών και σε ορισμένες περιπτώσεις την βελτίωση της επιβίωσης. Σε μία πρόσφατη δημοσίευση στο διεθνές περιοδικό «Microorgansims» τον Απρίλιο 2021, από ομάδα ερευνητών του ΕΚΠΑ με τη συμμετοχή των Καθηγητριών και Καθηγητών της Ιατρικής Σχολής, Βασιλική Παππά, Ευάγγελο Τέρπο, Αναστασία Αντωνιάδου, Αναστασία Κοτανίδου, Μαριάννα Πολίτου, Ιωάννη Καλομενίδη, Γαρυφαλλιά Πουλάκου, Αριστοτέλη Μπάμια, Σωτήριο Τσιόδρα και Θάνο Δημόπουλο (Πρύτανης ΕΚΠΑ), μίας προοπτικής μελέτης που διεξήχθη σε 5 Νοσοκομεία της Αθήνας, ανακοινώθηκαν τα αρχικά αποτελέσματα της χορήγησης πλάσματος ιαθέντων, στους πρώτους 60 ασθενείς.

Η μελέτη περιέλαβε ασθενείς με σοβαρή μορφή της νόσου και με διάρκεια συμπτωμάτων μικρότερη των 10 ημερών καθώς και διασωληνωμένους ασθενείς για χρονική διάρκεια μικρότερη των 72 ωρών. Η μελέτη αυτή έδειξε ότι η χορήγηση πλάσματος ιαθέντων σε νοσηλευόμενους ασθενείς με σοβαρή μορφή COVID-19 είχε πολύ θετικά αποτελέσματα. Συγκεκριμένα σε 60 ασθενείς οι οποίοι έλαβαν πλάσμα ιαθέντων και την καθιερωμένη θεραπεία, σε σύγκριση με μία ομάδα 59 ασθενών που είχαν τα ίδια κλινικά χαρακτηριστικά και έλαβαν την καθιερωμένη θεραπεία χωρίς πλάσμα, εδείχθη ότι η θνητότητα των ασθενών που έλαβαν πλάσμα ήταν μικρότερη (3.4% σε σύγκριση με 13.6% στην ομάδα ελέγχου) στη διάρκεια παρακολούθησης της μελέτης. Επίσης η στατιστική ανάλυση έδειξε ότι οι ασθενείς που έλαβαν πλάσμα ιαθέντων είχαν σημαντικά μικρότερο κίνδυνο θανάτου, σημαντικά καλύτερη επιβίωση και σημαντικά μεγαλύτερες πιθανότητες να αποσωληνωθούν. Επιπλέον οι υψηλοί τίτλοι αντισωμάτων στο πλάσμα ιαθέντων, είχαν σαν αποτέλεσμα την σημαντικά καλύτερη επιβίωση των ασθενών. Η μελέτη έχει ολοκληρωθεί με την ένταξη 113 ασθενών και τα αποτελέσματα αναμένονται με ενδιαφέρον.
Αν και η ευεγερτική χορήγηση πλάσματος δεν έχει επιβεβαιωθεί από μεγάλες τυχαιοποιημένες μελέτες, εντούτοις μία αναδρομική ανάλυση 3082 ασθενών στις ΗΠΑ που έλαβαν πλάσμα ιαθέντων για σοβαρή COVID-19 ενωρίς από την έναρξη των συμπτωμάτων, έδειξε σημαντική μείωση της θνητότητας για τους μη διασωληνωμένους ασθενείς που έλαβαν πλάσμα το οποίο περιείχε υψηλούς τίτλους αντι-SARS-CoV-2 αντισωμάτων. Με βάση τα αποτελέσματα αυτά το FDA τροποποίησε την αδειοδότηση για επείγουσα χορήγηση πλάσματος ιαθέντων που περιέχει υψηλούς τίτλους αντισωμάτων σε ασθενείς με σοβαρή λοίμωξη COVID-19 και ενωρίς στην πορεία της νόσου καθώς και για ασθενείς οι οποίοι έχουν μειωμένη ικανότητα παραγωγής αντισωμάτων λόγω ανοσοκαταστολής.
Οι ασθενείς με αιματολογικές νεοπλασίες παρουσιάζουν σοβαρές διαταραχές της ανοσίας τους είτε λόγω της ασθένειας είτε λόγω χορήγησης θεραπείας με παράγοντες που καταστέλλουν τη λειτουργία του ανοσοποιητικού συστήματος και οδηγούν μεταξύ άλλων και στην μειωμένη παραγωγή αντισωμάτων. Η ανεπάρκεια αυτή του ανοσοποιητικού συστήματος στους ασθενείς με Αιματολογικές κακοήθειες ( όπως Χρόνια Λεμφική Λευχαιμία, Πολλαπλούν Μυέλωμα, Οξείες λευχαιμίες, Λεμφώματα και άλλα) έχει σαν αποτέλεσμα την αυξημένη συχνότητα επιπλοκών της COVID-19 και την αυξημένη θνητότητα των ασθενών. Με βάση το δεδομένο αυτό ερευνητές από το Vanderbilt Universtiy στο Nashvillle των ΗΠΑ, εκπόνησαν αναδρομική πολυκεντρική μελέτη χορήγησης πλάσματος ιαθέντων σε νοσηλευόμενους ασθενείς με αιματολογικές νεοπλασίες και COVID-19. Τα δεδομένα των ασθενών ελήφθησαν από την κοινή βάση καταγραφής ασθενών με COVID-19 και Καρκίνο. Tα αποτελέσματα της μελέτης ανακοινώθηκαν στο περιοδικό JAMA Oncology στις 17 Ιουνίου 2021 με πρώτο συγγραφέα τον Michael A. Thompson.Ο στόχος της μελέτης ήταν να εκτιμηθεί η θνητότητα την ημέρα 30, 134 ασθενών με αιματολογικές νεοπλασίες και COVID-19 που έλαβαν την ενδεικνυόμενη αγωγή σε συνδυασμό με πλάσμα ιαθέντων. Οι ασθενείς συγκρίθηκαν με ομάδα ελέγχου 823 ασθενών με τα ίδια κλινικά χαρακτηριστικά, που έλαβαν μόνο την ενδεικνυόμενη αγωγή. Η στατιστική ανάλυση έδειξε ότι η χορήγηση πλάσματος είχε ως αποτέλεσμα την σημαντική μείωση του κινδύνου θανάτου την 30η ημέρα κατά 40%., την σημαντική μείωση κατά 60% της θνητότητας για τους 338 ασθενείς που νοσηλεύονταν στη Μονάδα Εντατικής Θεραπείας καθώς τη σημαντική μείωση της θνητότητας κατά 68%, για τους 227 ασθενείς που χρειάζονταν μηχανική υποστήριξη της αναπνοής.
Τα ευνοϊκά αυτά αποτελέσματα αναμένεται να επιβεβαιωθούν μέσα από τυχαιοποιημένες μελέτες και για τον σκοπό αυτό σχεδιάζεται στην Αθήνα μία νέα τυχαιοποιημένη μελέτη ασθενών με αιματολογικές νεοπλασίες οι οποίοι νοσηλεύονται με μέτρια ή σοβαρή μορφή της COVID-19 και οι οποίοι κατά τυχαίο τρόπο, θα λάβουν την ενδεικνυόμενη αγωγή σε συνδυασμό με πλάσμα ιαθέντων ή μόνο την ενδεικνυόμενη αγωγή. Η μελέτη πρόκειται σύντομα να ξεκινήσει υπό την αιγίδα της Ιατρικής Σχολής του ΕΚΠΑ, με κύριους ερευνητές τις Καθηγήτριες Βασιλική Παππά και Μαριάννα Πολίτου και τον Καθηγητή Ευάγγελο Τέρπο και τη συμμετοχή 5 Νοσοκομείων των Αθηνών που χειρίζονται ασθενείς με αιματολογικά νεοπλάσματα. Η μελέτη αυτή αναμένεται να στοιχειοθετήσει την ένδειξη για την χορήγηση της θεραπείας με πλάσμα ιαθέντων, σε αυτή την ευάλωτη ομάδα ασθενών με μειωμένη ικανότητα παραγωγής αντισωμάτων και συνεπώς μη ικανοποιητικό έλεγχο της λοίμωξης COVID-19.